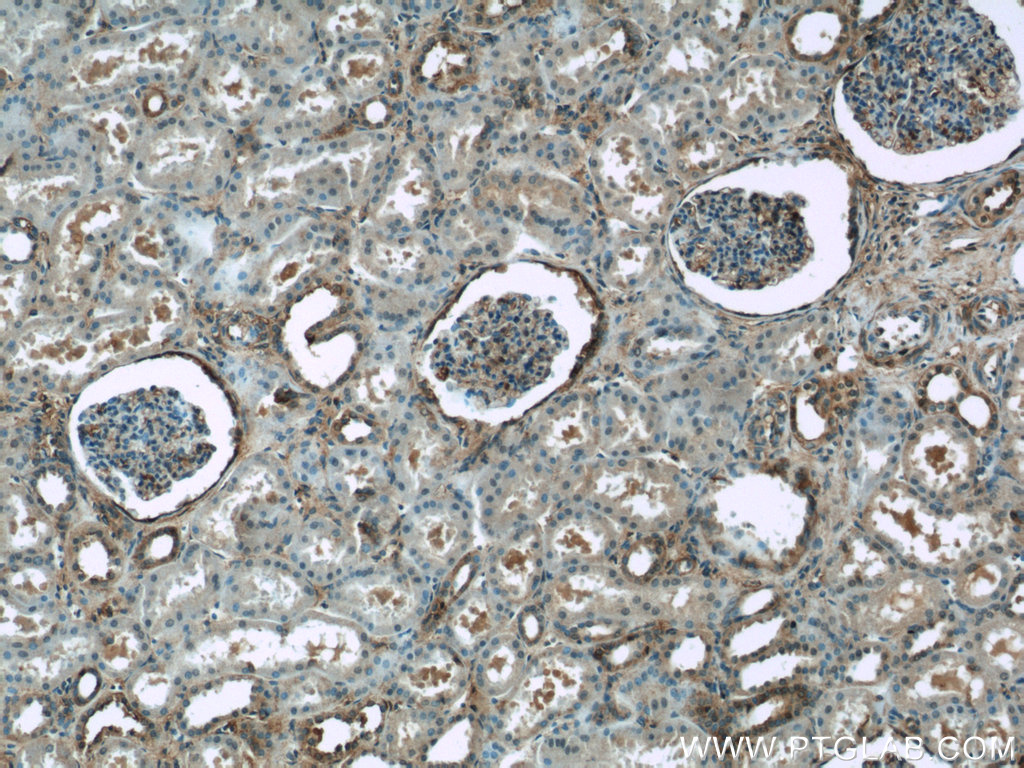

验证数据展示
经过测试的应用
| Positive WB detected in | HepG2 cells, mouse liver tissue, A549 cells, human liver tissue, MCF-7 cells, HEK-293 cells, rat liver tissue |
| Positive IHC detected in | human liver cancer tissue, human colon tissue, human heart tissue, human kidney tissue Note: suggested antigen retrieval with TE buffer pH 9.0; (*) Alternatively, antigen retrieval may be performed with citrate buffer pH 6.0 |
| Positive IF/ICC detected in | PC-3 cells |
推荐稀释比
| 应用 | 推荐稀释比 |
|---|---|
| Western Blot (WB) | WB : 1:1000-1:4000 |
| Immunohistochemistry (IHC) | IHC : 1:50-1:500 |
| Immunofluorescence (IF)/ICC | IF/ICC : 1:200-1:800 |
| It is recommended that this reagent should be titrated in each testing system to obtain optimal results. | |
| Sample-dependent, Check data in validation data gallery. | |
产品信息
20225-1-AP targets ARF6-Specific in WB, IHC, IF/ICC, ELISA applications and shows reactivity with human, mouse, rat samples.
| 经测试应用 | WB, IHC, IF/ICC, ELISA Application Description |
| 文献引用应用 | WB, IHC, IF |
| 经测试反应性 | human, mouse, rat |
| 文献引用反应性 | human, mouse |
| 免疫原 |
Peptide 种属同源性预测 |
| 宿主/亚型 | Rabbit / IgG |
| 抗体类别 | Polyclonal |
| 产品类型 | Antibody |
| 全称 | ADP-ribosylation factor 6 |
| 别名 | ARF6, ADP ribosylation factor 6, ADP-ribosylation factor 6, EC:3.6.5.2 |
| 计算分子量 | 20 kDa |
| 观测分子量 | 20 kDa |
| GenBank蛋白编号 | NM_001663 |
| 基因名称 | ARF6 |
| Gene ID (NCBI) | 382 |
| RRID | AB_10646481 |
| 偶联类型 | Unconjugated |
| 形式 | Liquid |
| 纯化方式 | Antigen affinity purification |
| UNIPROT ID | P62330 |
| 储存缓冲液 | PBS with 0.02% sodium azide and 50% glycerol, pH 7.3. |
| 储存条件 | Store at -20°C. Stable for one year after shipment. Aliquoting is unnecessary for -20oC storage. |
背景介绍
ADP-ribosylation factors (ARFs) are members of the ARF family of GTP-binding proteins of the Ras superfamily, with 20 kDa protein size. ARFs bind and regulate GTP/GDP cycle by alternating between the active GTP-bound and inactive GDP-bound conformations. ARF family proteins are essential and ubiquitous in eukaryotes. Six highly conserved members of the family have been identified in mammalian cells. They function in vesicular traffic and actin remodelling and other bioprocesses in cells. The ARF6 is one of best identified ARFs It is present at the plasma membrane and to some extent on endosomal membranes where it regulates the flow of trafficking into and out of the cell and the actin cytoskeleton. The antibody is specific to ARF6.
实验方案
| Product Specific Protocols | |
|---|---|
| IF protocol for ARF6-Specific antibody 20225-1-AP | Download protocol |
| IHC protocol for ARF6-Specific antibody 20225-1-AP | Download protocol |
| WB protocol for ARF6-Specific antibody 20225-1-AP | Download protocol |
| Standard Protocols | |
|---|---|
| Click here to view our Standard Protocols |
发表文章
| Species | Application | Title |
|---|---|---|
Int J Biol Sci Platelet-derived extracellular vesicles aggravate septic acute kidney injury via delivering ARF6
| ||
Arterioscler Thromb Vasc Biol BIG1, a brefeldin A-inhibited guanine nucleotide-exchange protein modulates ATP-binding cassette transporter A-1 trafficking and function. | ||
Int J Mol Sci Distribution of Signal Peptides in Microvesicles from Activated Macrophage Cells | ||
Sci Rep Differential regulation of synaptic AP-2/clathrin vesicle uncoating in synaptic plasticity. | ||
PLoS One TNF Stimulates Nuclear Export and Secretion of IL-15 by Acting on CRM1 and ARF6. |